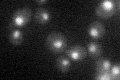
YGR013W
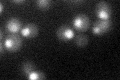
YGR013W

View description
Component of U1 snRNP required for mRNA splicing via spliceosome; yeast specific, no metazoan counterpart
Localization:
Intensity:
Fold change:
Significance:
-
C’ GFP library in SD
nucleus26.71 -
N' NOP1pr-GFP in SD

cytosol,nucleus96.2927 -
N' TEF2pr-mCherry in SD

nucleus95.4148 -
N' NATIVEpr-GFP in SD

nucleus30.4178 -
N' TEF2pr-VC and Cyto-VN in SD

#N/A0 -
C’ GFP library in SD+DTT

nucleus28.691.07No -
C’ GFP library in SD+H2O2
nucleus26.630.99No -
C’ GFP library in Starvation Media

nucleus28.331.06No -
C’ GFP library on the background of Pup2-DaMP

nucleus -
C’ GFP library on the background of CCT mutant

nucleus27.18211.01754No
